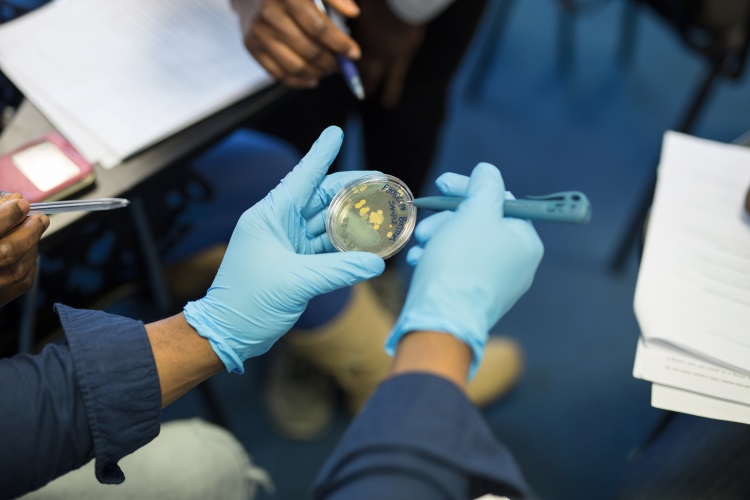
Food Business Degree

Got the Appetite for Success? Use Your Business Degree in the Food Science Industry
Are you a business graduate who wants to get more out of your degree? Innopharma Education MSc in Food Business & Technology could be just the course for you.
Food science is set to become one of the most important industries of the 21st century, as scientists, researchers and technicians respond to new challenges in safety, sustainability, and health around the globe. And Ireland is set to be at the heart of this exciting industry. The Food & Beverages sector is already thriving here and is set to get even bigger, with the national Harvest 2020 strategy aiming to increase exports by 42% over the next five years – reaching a total of €12bn.
The MSc in Food Business & Technology is our only Master’s programme that’s open to business graduates and is specifically designed to give candidates with a pre-existing qualification the skillset they need to be a success in this exciting sector.
The programme consists of eight modules and a final research-based thesis project. And to make it even more convenient for students, it’s delivered online through a combination of seminars, tutorials, and practicals. The course commences in January 2017 and runs for 12 months over three semesters.
In semester one, students will learn the basics of food science, study the legal and regulatory framework of the global food business, and examine the global food supply chain. In semester two the course moves on to food formulations & processing, R&D product management, and looks to the future by highlighting 21st century-trends in the global food industry. The final semester is reserved for work on the thesis-based assignment.
On completion of the course, you’ll be able to describe in detail the life-cycle within the food industry and guiding principles within which the sector operates, define the requirements of international food quality assurance systems and legal implications that meet the requirements of the regulatory agencies. You’ll also have the knowledge to apply the processes of food innovation methodology to identify new products to the market, develop and implement sales and marketing strategies, and identify current trends in best practice for food nutrition.
As an MSc in Food Business & Technology graduate, you’ll be equipped with a CV which will allow you to apply for roles in sales and marketing management, quality/regulatory affairs, supply chain and project/process management and many other areas in the food science sector. And our Professional Development team will make sure you find the perfect job for you, providing networking, communication, and presentation advice and guiding you along a career path that’s designed to make the most of your potential. It works too – over 70% of Innopharma graduates gain employment within six months of qualification.
If you’re a business graduate that’s looking to take a new and exciting step in your career, the MSc in Food Business & Technology is the gateway to a new world of possibilities in one of the fastest growing sectors in world business.
Interested in applying right now?
Visit our website to inquire about the MSc in Food Business & Technology or call us today on +353 1 485 3346 to learn more.



















